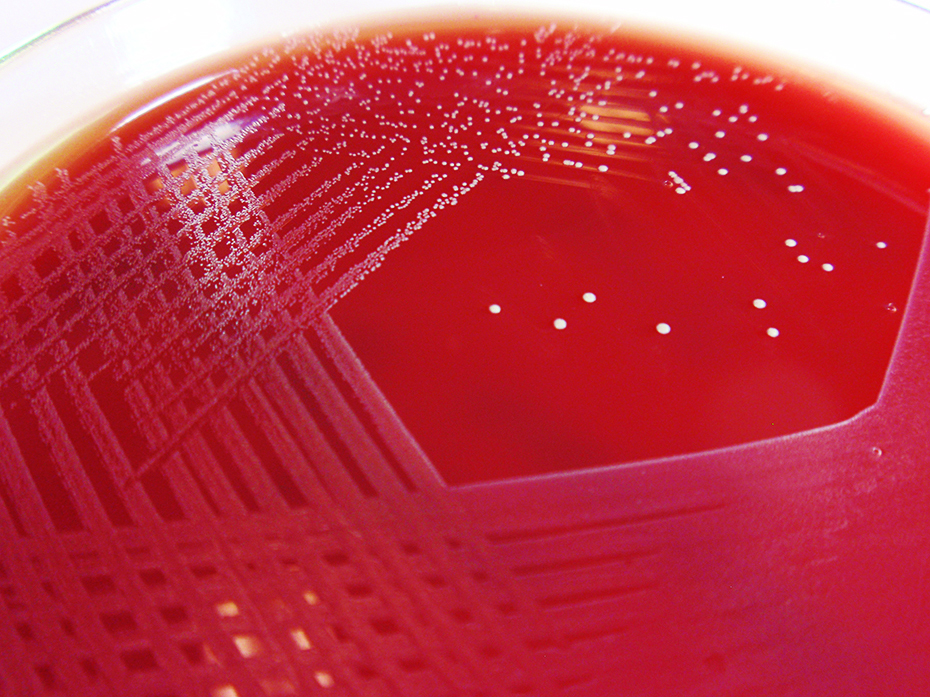
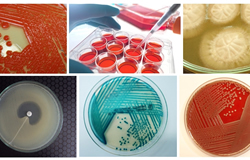

Z7_NQ5E12C0L00460A1F5MQ530HQ0
Portal U de A - Cabezote - WCV(JSR 286)
Z7_NQ5E12C0L00460A1F5MQ530HQ1
Index Signpost
Microba
Z7_NQ5E12C0L00460A1F5MQ530HQ3
UdeA - Rotador Interno (Home2) - WCV(JSR 286)
-
Grupo de Investigación en Microbiología Básica y Aplicada - MICROBA
Z7_NQ5E12C0L00460A1F5MQ530H60
Portal U de A - Home 2 - Redes Sociales - WCV(JSR 286)
Z7_NQ5E12C0L00460A1F5MQ530H62
UdeA - Título de sección - WCV(JSR 286)
Grupo de Investigación en Microbiología Básica y Aplicada
Z7_NQ5E12C0L00460A1F5MQ530H61
Portal U de A - Destacados Home 2 - WCV(JSR 286)
Z7_NQ5E12C0L00460A1F5MQ530H63
UdeA - Título de sección - WCV(JSR 286)
También te puede interesar
Z7_NQ5E12C0L00460A1F5MQ530HM0
Listado Home 2
Sin resultados
Z7_NQ5E12C0L00460A1F5MQ530HM2
Footer - Udea - JSR(286)
Z7_NQ5E12C0L00460A1F5MQ530HM1